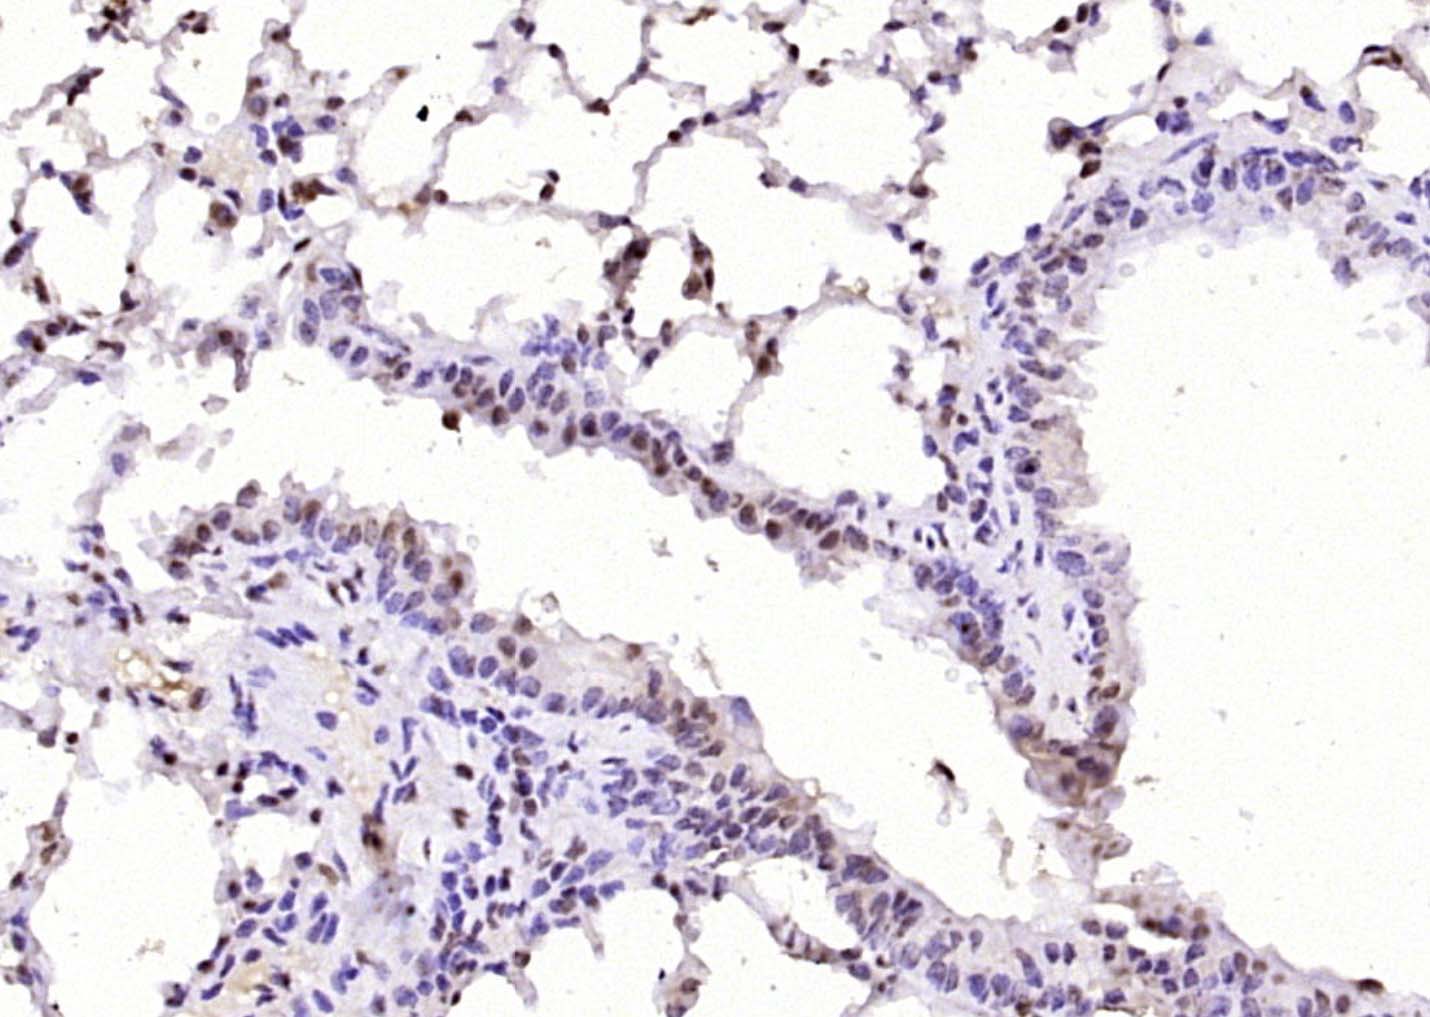
产品细节图片2

相关产品推荐更多 >

TTR/Prealbumin Mouse mAb, Biotin conjugated(bsm-33369M-Bio)-100ul
¥2980
Synaptopodin Rabbit pAb, PE conjugated(bs-3633R-PE)-100ul
¥2980
PEX7 Rabbit pAb, AP conjugated(bs-19913R-AP)-100ul
¥2980
Glutaminase Recombinant Rabbit mAb(bsm-60888R)-50ul/100ul/25ul
¥800
SARA Rabbit pAb(bs-19393R)-50ul/100ul/200ul
¥1180
万千商家帮你免费找货
0 人在求购买到急需产品
- 详细信息
- 文献和实验
- 技术资料
- 应用范围:
产品信息以Bioss网站为准
- 规格:
50ul/100ul/200ul
| 规格: | 50ul | 产品价格: | ¥1180.0 |
|---|---|---|---|
| 规格: | 100ul | 产品价格: | ¥1980.0 |
| 规格: | 200ul | 产品价格: | ¥2800.0 |
| 产品编号 | bs-13686R |
| 英文名称 | KAT5 / Tip60 Rabbit pAb |
| 中文名称 | TIP60抗体 |
| 英文别名 | Tip60; 60 kDa Tat interactive protein; 60 kDa Tat-interactive protein; cPLA(2) interacting protein; cPLA(2)-interacting protein; cPLA2; cPLA2 interacting protein; ESA1; Histone acetyltransferase HTATIP; Histone acetyltransferase KAT5; HIV1 tat; HIV 1 Tat interactive protein; HIV 1 Tat interactive protein, 60kDa; HIV-1 Tat interactive protein; HTATIP; HTATIP1; K(lysine) acetyltransferase 5; K-acetyltransferase 5; KAT5; KAT5_HUMAN; Lysine acetyltransferase 5; PLIP; Tat interacting protein, 60kDa; TIP. |
| 产品应用 | WB=1:500-2000, IHC-P=1:100-500, IHC-F=1:100-500, IF=1:100-500 Not yet tested in other applications. |
| 交叉反应 | Mouse, Rat (Human, Dog, Pig, Horse, Rabbit, Sheep) |
| 抗体来源 | Rabbit |
| 免疫原 | KLH conjugated synthetic peptide derived from human KAT5 / Tip60 |
| 亚型 | IgG |
| 性状 | Liquid |
| 纯化方法 | affinity purified by Protein A |
| 克隆类型 | Polyclonal |
| 理论分子量 | 59 kDa |
| 浓度 | 1mg/ml |
| 储存液 | 0.01M TBS (pH7.4) with 1% BSA, 0.02% Proclin300 and 50% Glycerol. |
| 亚细胞定位 | Nucleus > nucleolus. Cytoplasm > perinuclear region. Upon stimulation with EDN1, it is exported from the nucleus to the perinuclear region and UV irradiation induces translocation into punctuate subnuclear structures named nuclear bodies. |
| 翻译后修饰 | Sumoylated by UBE2I at Lys-430 and Lys-451, leading to increase of its histone acetyltransferase activity in UV-induced DNA damage response, as well as its translocation to nuclear bodies. Phosphorylated on Ser-86 and Ser-90; enhanced during G2/M phase. Phosphorylated form has a higher activity. Ubiquitinated by MDM2, leading to its proteasome-dependent degradation. |
| 相似性 | Belongs to the MYST (SAS/MOZ) family. Contains 1 C2HC-type zinc finger. |
| 功能 | Catalytic subunit of the NuA4 histone acetyltransferase complex which is involved in transcriptional activation of select genes principally by acetylation of nucleosomal histones H4 and H2A. This modification may both alter nucleosome-DNA interactions and promote interaction of the modified histones with other proteins which positively regulate transcription. This complex may be required for the activation of transcriptional programs associated with oncogene and proto-oncogene mediated growth induction, tumor suppressor mediated growth arrest and replicative senescence, apoptosis, and DNA repair. NuA4 may also play a direct role in DNA repair when recruited to sites of DNA damage. Directly acetylates and activates ATM. In case of HIV-1 infection, interaction with the viral Tat protein leads to KAT5 polyubiquitination and targets it to degradation. |
| 保存条件 | Shipped at 4℃. Store at -20℃ for one year. Avoid repeated freeze/thaw cycles. |
| 注意事项 | This product as supplied is intended for research use only, not for use in human, therapeutic or diagnostic applications. |
| 背景资料 | The protein encoded by this gene belongs to the MYST family of histone acetyl transferases (HATs) and was originally isolated as an HIV-1 TAT-interactive protein. HATs play important roles in regulating chromatin remodeling, transcription and other nuclear processes by acetylating histone and nonhistone proteins. This protein is a histone acetylase that has a role in DNA repair and apoptosis and is thought to play an important role in signal transduction. Alternative splicing of this gene results in multiple transcript variants. [provided by RefSeq, Jul 2008] |
| 应用 | 推荐稀释比例 |
| {WB} | {1:500-2000} |
| {IHC-P} | {1:100-500} |
| {IHC-F} | {1:100-500} |
| {IF} | {1:100-500} |

Lane 1: Mouse Cerebrum tissue lysates
Lane 2: Mouse Stomach tissue lysates
Lane 3: Mouse Liver tissue lysates
Lane 4: Rat Cerebrum tissue lysates
Lane 5: Rat Stomach tissue lysates
Primary: Anti-KAT5 / Tip60 (bs-13686R) at 1/1000 dilution
Secondary: IRDye800CW Goat Anti-Rabbit IgG at 1/20000 dilution
Predicted band size: 59 kDa
Observed band size: 59 kDa
风险提示:丁香通仅作为第三方平台,为商家信息发布提供平台空间。用户咨询产品时请注意保护个人信息及财产安全,合理判断,谨慎选购商品,商家和用户对交易行为负责。对于医疗器械类产品,请先查证核实企业经营资质和医疗器械产品注册证情况。
文献和实验[IF={{ 5.9 }}] {Liu Can. et al. STUB1 is acetylated by KAT5 and alleviates myocardial ischemia-reperfusion injury through LATS2-YAP-β-catenin axis. COMMUN BIOL. 2024 Apr;7(1):1-14} {WB,IHC} {Mouse,Human}
[IF={{ 5.418 }}] {Hye Young Ryu. et al. GSK3B induces autophagy by phosphorylating ULK1. Exp Mol Med. 2021 Mar;:1-15} {WB} {Rat}
[IF={{ 4.556 }}] {Wu W et al. Tip60 Phosphorylation at Ser 99 Is Essential for Autophagy Induction in Bombyx mori. Int. J. Mol. Sci. 2020, 21, 6893.} {WB,IF} {human}
[IF={{ 4.556 }}] {Wenmei Wu. et al. Tip60 Phosphorylation at Ser 99 Is Essential for Autophagy Induction in Bombyx mori. Int J Mol Sci. 2020 Jan;21(18):6893} {WB,IP} {B. mori larvae}
[IF={{ 18.699 }}] {Yuan, Lin, et al. "Deubiquitylase OTUD3 regulates PTEN stability and suppresses tumorigenesis." Nature Cell Biology (2015).} {IHC} {="Mouse"}
Immunofluorescence: Rabbit Anti-Murine RELMα
for 25 minutes. 3. Incubate the tissue section with blocking buffer for 20 minutes. 4. Incubate the tissue section overnight at 4?C with Rabbit Anti-Murine RELMα at 4.0 ng/mL in 1X PBS with 0.01% Triton-X and 0.5% BSA. Wash the slide
ChIP protocol for X. laevis Lens1/FoxE3 enhancer
(9) Sonicate the homogenate on ice (10 sec. pulse + 50 sec. break x 6 times, 20% amplitude with a small tip of Branson sonifier (Fisher Dismembranator Model 500)). This step releases chromatin DNA from cells without solubilizing yolk proteins that make
Immunoprecipitation of Proteins
to cells (1 ml per 107 cells/100 mm dish/150 cm2 flask; 0.5 ml per 5 x106 cells/60 mm dish/75 cm2 flask). 3.Scrape adherent cells off the dish or flask with either a rubber policeman or a plastic cell scraper that has been cooled in ice-cold distilled
技术资料暂无技术资料 索取技术资料






